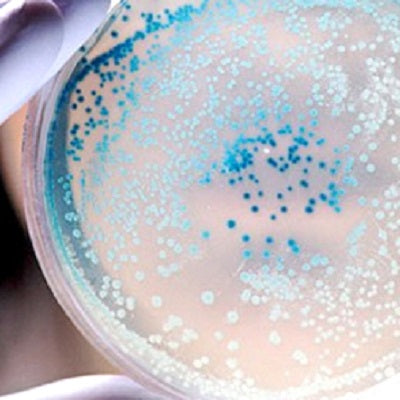

Yemoos Blog

Crafting Maple Syrup Water Kefir - A Step-by-Step Guide
September 20, 2023 1 Comment

The wonderful benefits of Paraprobiotics
February 11, 2023

Why you should ripen your kefir
December 05, 2021 1 Comment

Kefir VS Coronavirus (COVID-19)
March 09, 2020 3 Comments
How many probiotics (CFUs) are in water kefir?
December 16, 2019 2 Comments

Kefir prevents mold contamination
November 26, 2019

Open or Closed Lid for Water Kefir Fermenting?
November 16, 2019 6 Comments

Which vegetable juices work best with water kefir?
October 04, 2019 3 Comments

How much kefir should I drink each day?
September 10, 2019 10 Comments

Does Homemade Kombucha have probiotics?
August 18, 2019 3 Comments
Does Homemade Kombucha have probiotics? The surprising answer is that experts are not really sure if it does have probiotics or not.

Can Kefir help anxiety and depression?
August 04, 2019 3 Comments

Lactic Acid Bacteria vs Acetic Acid Bacteria
July 02, 2019 2 Comments